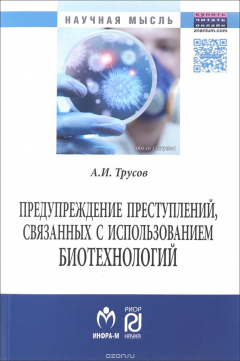
книга Предупреждение преступлений, связанных с использованием биотехнологий

Предупреждение преступлений, связанных с использованием биотехнологий
-
Сейчас читают
-
Отложили
-
Прочитали
-
Не дочитали
Автор:
Биотехнологическая революция предоставила широкие возможности гуманистического использования результатов открытий. Однако в среднесрочной перспективе следует ожидать появления совершенно новых для России преступлений, связанных с нелегальным использованием современных...Ещё
Биотехнологическая революция предоставила широкие возможности гуманистического использования результатов открытий. Однако в среднесрочной перспективе следует ожидать появления совершенно новых для России преступлений, связанных с нелегальным использованием современных биотехнологий. Монография рассчитана на курсантов, студентов, адъюнктов, аспирантов, соискателей, занимающихся исследованиями в данных областях. Также может быть использована преподавателями и научными сотрудниками вузов.
- ИНФРА-М
- 2015 г.
- 16+
- 9785160107431
Материалы
Отзывы
Раз в месяц дарим подарки самому активному читателю.Оставляйте больше отзывов, и мы наградим вас!
Цитаты
Вы можете первыми опубликовать цитату
Где найти
-
579,00 ₽